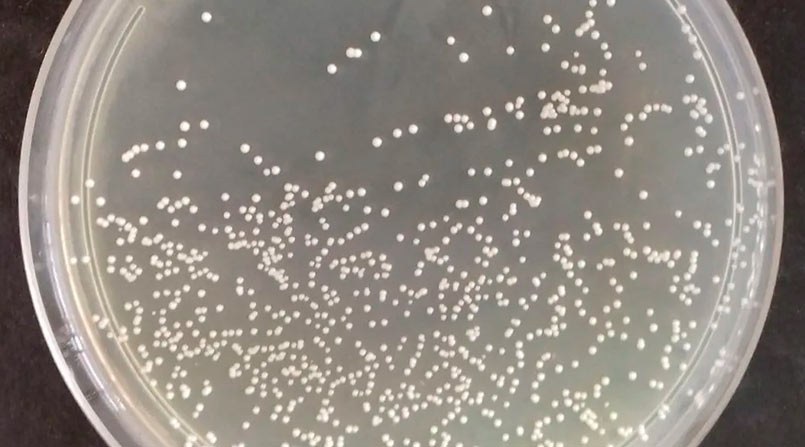
Seu intestino pede ajuda? Entenda como escolher um probiótico

Blog
Confira meus artigos de blog

Doença Inflamatória Intestinal: como perceber os sinais e quando buscar ajuda especializada.
O texto reforça que tratar refluxo não é sinônimo de viver refém de remédio. O jogo vira quando o paciente entende que o pilar mais consistente do controle da DRGE está nas mudanças de hábitos, com diagnóstico bem amarrado por especialista e medicação entrando como apoio quando necessário (e geralmente por tempo definido).
Na prática, o artigo consolida as recomendações da diretriz brasileira (FBG/2024): perda de peso quando há sobrepeso/obesidade (reduz pressão no abdômen e melhora a função do esfíncter), elevar a cabeceira (~15 cm) para reduzir sintomas noturnos, parar de fumar e reduzir/cessar álcool por impacto direto na válvula e na acidez. Também orienta não deitar logo após comer (esperar 2–3 horas), ajustar gatilhos alimentares (cada paciente tem o seu “mapa” de piora) e evitar deitar do lado direito, posição que favorece o retorno do ácido.

Dieta Low FODMAP: o que é, para quem serve e como ajuda nos sintomas intestinais
O texto reforça que tratar refluxo não é sinônimo de viver refém de remédio. O jogo vira quando o paciente entende que o pilar mais consistente do controle da DRGE está nas mudanças de hábitos, com diagnóstico bem amarrado por especialista e medicação entrando como apoio quando necessário (e geralmente por tempo definido).
Na prática, o artigo consolida as recomendações da diretriz brasileira (FBG/2024): perda de peso quando há sobrepeso/obesidade (reduz pressão no abdômen e melhora a função do esfíncter), elevar a cabeceira (~15 cm) para reduzir sintomas noturnos, parar de fumar e reduzir/cessar álcool por impacto direto na válvula e na acidez. Também orienta não deitar logo após comer (esperar 2–3 horas), ajustar gatilhos alimentares (cada paciente tem o seu “mapa” de piora) e evitar deitar do lado direito, posição que favorece o retorno do ácido.

Dra. Louise Deluiz Verdolin Di Palma fala ao Terra sobre sintomas silenciosos da gordura no fígado
O texto reforça que tratar refluxo não é sinônimo de viver refém de remédio. O jogo vira quando o paciente entende que o pilar mais consistente do controle da DRGE está nas mudanças de hábitos, com diagnóstico bem amarrado por especialista e medicação entrando como apoio quando necessário (e geralmente por tempo definido).
Na prática, o artigo consolida as recomendações da diretriz brasileira (FBG/2024): perda de peso quando há sobrepeso/obesidade (reduz pressão no abdômen e melhora a função do esfíncter), elevar a cabeceira (~15 cm) para reduzir sintomas noturnos, parar de fumar e reduzir/cessar álcool por impacto direto na válvula e na acidez. Também orienta não deitar logo após comer (esperar 2–3 horas), ajustar gatilhos alimentares (cada paciente tem o seu “mapa” de piora) e evitar deitar do lado direito, posição que favorece o retorno do ácido.

Refluxo gastroesofágico: medidas comportamentais que ajudam de verdade
O texto reforça que tratar refluxo não é sinônimo de viver refém de remédio. O jogo vira quando o paciente entende que o pilar mais consistente do controle da DRGE está nas mudanças de hábitos, com diagnóstico bem amarrado por especialista e medicação entrando como apoio quando necessário (e geralmente por tempo definido).
Na prática, o artigo consolida as recomendações da diretriz brasileira (FBG/2024): perda de peso quando há sobrepeso/obesidade (reduz pressão no abdômen e melhora a função do esfíncter), elevar a cabeceira (~15 cm) para reduzir sintomas noturnos, parar de fumar e reduzir/cessar álcool por impacto direto na válvula e na acidez. Também orienta não deitar logo após comer (esperar 2–3 horas), ajustar gatilhos alimentares (cada paciente tem o seu “mapa” de piora) e evitar deitar do lado direito, posição que favorece o retorno do ácido.

Como posso ter dor no estômago se minha endoscopia é normal?
Aqui a mensagem central é super didática: dá, sim, pra ter dor/queimação/desconforto no estômago com endoscopia normal — e, em grande parte dos casos de dispepsia, isso aponta para dispepsia funcional (idiopática/não ulcerosa), que responde por cerca de 75% a 80% dos quadros. O diagnóstico é principalmente clínico, baseado na história e nos critérios de sintomas.
O artigo lista os sintomas mais comuns: plenitude pós-prandial (estômago “cheio” após comer), saciedade precoce, dor epigástrica e queimação. Para fechar o raciocínio, reforça a linha do tempo (sintomas iniciados há pelo menos 6 meses e presentes nos últimos 3). Também mapeia fatores de risco/associação: maior ocorrência em mulheres, adultos jovens, tabagismo, IMC elevado, histórico de gastroenterite aguda (dispepsia pós-infecciosa) e comorbidades psiquiátricas como ansiedade/depressão/somatização. Fecha com um direcionamento bem “plano de ação”: existe tratamento combinando ajustes de estilo de vida, medicações e, quando indicado, suporte psicológico — e o paciente não deve normalizar sintomas crônicos.

Azia crônica: quando procurar ajuda?
O artigo enquadra a azia crônica como um sinal comum da DRGE, com impacto relevante em qualidade de vida e risco de complicações. Ele diferencia bem sintomas típicos (azia, regurgitação, dor/desconforto torácico) e atípicos (tosse seca noturna, rouquidão, dor de garganta recorrente, sensação de “bolo na garganta”, piora de asma e mau hálito), mostrando que refluxo pode se “disfarçar” e confundir.
Em termos de investigação, explica que o diagnóstico pode ser clínico em muitos casos, mas quando é preciso aprofundar entram exames como a endoscopia (avalia gravidade e complicações como estenose e esôfago de Barrett). E traz um ponto-chave: endoscopia normal não exclui refluxo, porque existe DRGE não erosiva. Nessa linha, a pHmetria de 24h aparece como exame “padrão ouro” para correlacionar acidez, frequência/duração do refluxo e sintomas no dia a dia. Fechamento bem direto: evitar automedicação e procurar avaliação especializada é o caminho para ajustar tratamento e reduzir risco no longo prazo.
Seu intestino pede ajuda? Entenda como escolher um probiótico
Probióticos não são todos iguais. Entenda como escolher a cepa correta, quando suplementar e por que a orientação médica faz toda a diferença.

Café com leite faz bem? Veja a proporção ideal e quem deve evitar
Café com leite pode ser saudável, mas exige moderação. Veja a proporção ideal, cuidados com nutrientes e quem deve evitar essa combinação.

